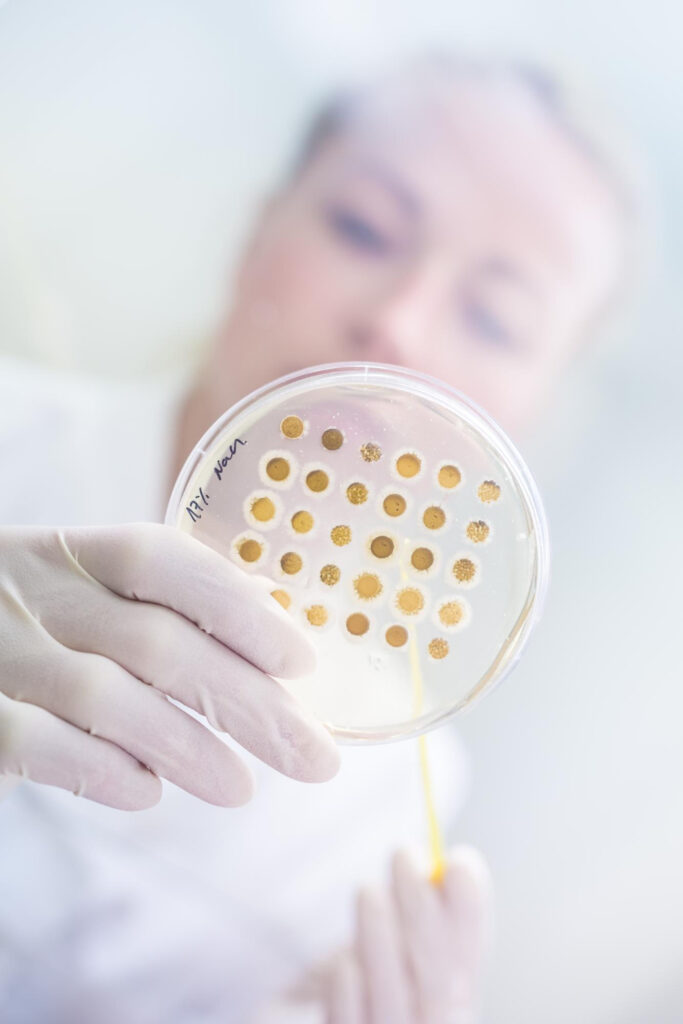

Die Exosomen-Therapie ist eine moderne biotechnologische Behandlung, die zelluläre Vesikel (Exosomen) verwendet – winzige Botenstoffe, die Wachstumsfaktoren und Peptide zwischen Zellen transportieren.
Funktionsweise:
Exosomen übertragen über 200 Wachstumsfaktoren und Signalmoleküle.
Sie aktivieren Fibroblasten zur Kollagen- und Elastinbildung.
Dadurch verbessert sich Hautstruktur, Festigkeit und Glanz.
Anwendungsbereiche:
Hautverjüngung und Anti-Aging
Narben und Aknebehandlung
Nach Laser- oder Microneedling
Haarwachstumsförderung
Vorteile:
Biologisch sicher
Schnelle Zellregeneration
Sichtbar bessere Hautqualität
Langanhaltendes Ergebnis (bis zu 1 Jahr)
Jedes Verfahren wird individuell auf Ihre Ziele und Ihren Hauttyp abgestimmt, um die besten und natürlichsten Ergebnisse zu erzielen.
Zertifizierte Spezialisten wenden fortschrittliche medizinische Ästhetiktechniken an, um sichere, wirksame und angenehme Behandlungen zu gewährleisten.
Wir verwenden die neuesten von der FDA zugelassenen Geräte und Produkte, um sichtbare Verbesserungen mit minimalen Ausfallzeiten zu erzielen.
Unsere Behandlungen verbessern nicht nur Ihr Aussehen, sondern stärken auch Ihr Selbstbewusstsein und helfen Ihnen, sich jeden Tag wohl in Ihrer Haut zu fühlen.

Exosomen-Therapie gilt als eine der sichersten und modernsten Anti-Aging-Methoden.
„Wenn wir über ästhetische Chirurgie sprechen, würde ich sie als lebensverändernd beschreiben. Der Grund dafür ist, dass die Beseitigung von Problemen mit Ihrem Aussehen nicht nur Ihr Aussehen verschönert, sondern auch Ihr Selbstvertrauen stärkt.“
WhatsApp us